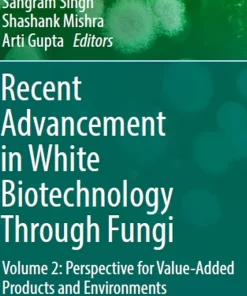
Recent Advancement in White Biotechnology Through Fungi

- +4 more
Shop
Showing 4663–4671 of 19601 results
Filter by price
Product categories
- Aids Books (6)
- Allergy Books (4)
- Alzheimer Book (38)
- AMC Books (13)
- Anatomy and Physiology (181)
- Anatomy Books (519)
- Anesthesia Books (469)
- Animal Biology Books (132)
- Asthma Books (107)
- Audiology Books (78)
- Bacteriology (95)
- Biochemistry Books (856)
- Biochemistry Physics Books (25)
- Bioelectronics Books (13)
- Bioethics Books (79)
- Bioinformatics Books (113)
- Biomechanics Books (49)
- Biometrics Books (15)
- Biophysics Books (32)
- Biopolymer Books (67)
- Biostatistics Books (61)
- Biotechnology Books (373)
- Blood Transfusion Books (36)
- Cardiology Books (1649)
- Cellular and Molecular Biology Books (204)
- Dental Books (10)
- Diabetes Books (56)
- Embryology Books (58)
- Endocrinology Books (145)
- Entomology Books (34)
- Epidemiology Books (335)
- Epilepsy Books (19)
- Family Medicine Books (8)
- FCPS Books (79)
- Fisheries and Aquaculture Books (49)
- Food Industry and Nutrition Books (352)
- Forensic Medicine Books (124)
- Gene Therapy Books (13)
- Genomics Books (23)
- Gynaecology Books (91)
- Histology Books (47)
- Human Genetics Books (182)
- Hygiene and Health Books (758)
- IBCLC Exam Books (9)
- Immunology Books (238)
- Infectious Disease Books (70)
- Internal Medicine Books (130)
- Laboratory Sciences Books (112)
- Medical Books (3098)
- Medical Documents books (9)
- Medical Education Books (544)
- Medical Informatics Books (39)
- Metabolics Books (19)
- Microbiology Books (167)
- MRCOG Books (39)
- Mrcp Books (29)
- Nephrology Books (393)
- Neurology Books (288)
- Non-Medical (2368)
- Nursing Books (1073)
- Nutrition Books (123)
- Oncology Books (269)
- Oxford Books (37)
- Paediatrics Books (69)
- Para-Clinical Science (157)
- Parasitology Books (17)
- Parkinson Books (4)
- Pharmacology Books (396)
- Pharmacy Books (338)
- Physiotherapy Books (13)
- Plab Books (11)
- Pre-Clinical Science (13)
- Proteomics Books (19)
- Pulmonology Books (69)
- Regenerative Medicine Books (14)
- Rehabilitation Books (49)
- Rheumatology Books (9)
- Scrub (35)
- Sports Medicine Books (188)
- Telemedicine and Health Books (27)
- Traditional Medicine Books (78)
- Tropical Medicine Books (3)
- Urology and Nephrology Books (66)
- Uworld & Usmle Books (15)
- Veterinary and Animal Science Books (1373)
Top Rated Products
Showing 15541–15570 of 19601 results
-

Re-thinking Water and Food Security Fourth Botin Foundation Water Workshop
د.إ833.00 Quick View Compare -

Reach-to-Grasp Behavior
د.إ297.00 Quick View Compare -

Reactivating Elements Chemistry Ecology Practice
د.إ111.00 Quick View Compare -

Reactive Oxygen Nitrogen and Sulfur Species in Plants
د.إ1,812.00 Quick View Compare -
Sale!

Reactive Oxygen Species
د.إ1,293.00Original price was: د.إ1,293.00.د.إ765.00Current price is: د.إ765.00. Quick View Compare -

Reactive Oxygen Species in Plant Biology
د.إ1,102.00 Quick View Compare -

Reading EEGs A Practical Approach 2nd Edition
Call for Price Quick View Compare -

Reading MRI of the Prostate A Practical Guide
د.إ753.00 Quick View Compare -

Reading Understanding and Applying Nursing Research 5th Edition
Call for Price Quick View Compare -

Real Option Analysis and Climate Change
د.إ646.00 Quick View Compare -

Real Solutions Weight Loss Workbook 2nd Edition
Call for Price Quick View Compare -

Real Time 3D Interventional Echocardiography
Call for Price Quick View Compare -

Real Time Deforestation Detection Using Ann and Satellite Images
د.إ323.00 Quick View Compare -

Real Time Three Dimensional Transesophageal Echocardiography A Step by Step Guide
Call for Price Quick View Compare -

Real-World Evidence in a Patient-Centric Digital Era
د.إ598.00 Quick View Compare -

Real-World Evidence in a Patient-Centric Digital Era
د.إ622.00 Quick View Compare -
Sale!

Real-World Evidence in a Patient-Centric Digital Era
د.إ622.00Original price was: د.إ622.00.د.إ60.00Current price is: د.إ60.00. Quick View Compare -

Realist Trials and Systematic Reviews 1st Edition
د.إ179.00 Quick View Compare -
Sale!

Reality Therapy For the 21st Century
د.إ1,176.00Original price was: د.إ1,176.00.د.إ77.00Current price is: د.إ77.00. Quick View Compare -

Rearrangements with Migration to Electrophilic Heteroatomic Centers
د.إ1,323.00 Quick View Compare -

Reasons Why People are Stupid
د.إ154.00 Quick View Compare -

Rebound Train Your Mind to Bounce Back Stronger from Sports Injuries
د.إ72.00 Quick View Compare -

Rebuilding Life after Brain Injury Dreamtalk
Call for Price Quick View Compare -
Recent Advancement in White Biotechnology Through Fungi
د.إ661.00 Quick View Compare -
Sale!

Recent Advancement of IoT Devices in Pollution Control and Health Applications
د.إ1,325.00Original price was: د.إ1,325.00.د.إ33.00Current price is: د.إ33.00. Quick View Compare -

Recent Advances and Future Perspectives of Microbial Metabolites
د.إ506.00 Quick View Compare -

Recent Advances in Cannabinoid Physiology and Pathology
د.إ705.00 Quick View Compare -

Recent Advances in Dermatology
Call for Price Quick View Compare -

Recent Advances in Mechanical Engineering Select Proceedings of ERCAM 2021
Call for Price Quick View Compare -

Recent Advances in Nanocarriers for Pancreatic Cancer Therapy
د.إ1,058.00 Quick View Compare
Recently Viewed Products
No recently viewed products to display












